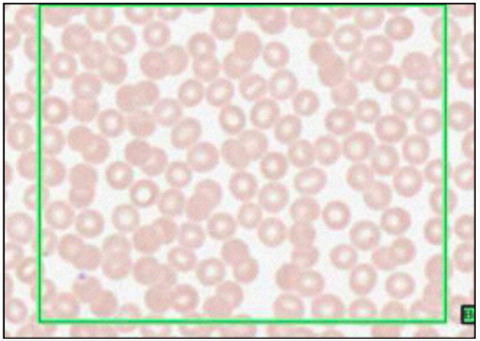
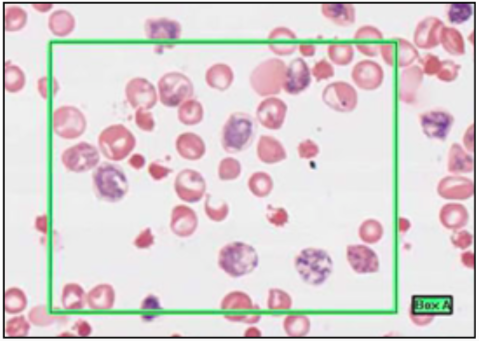
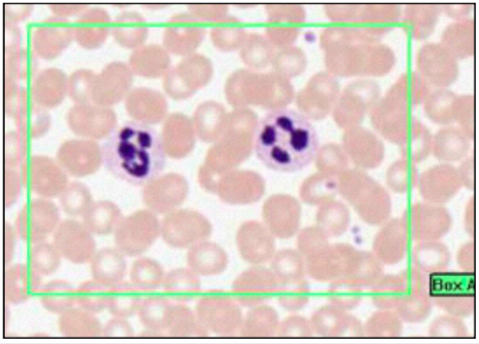
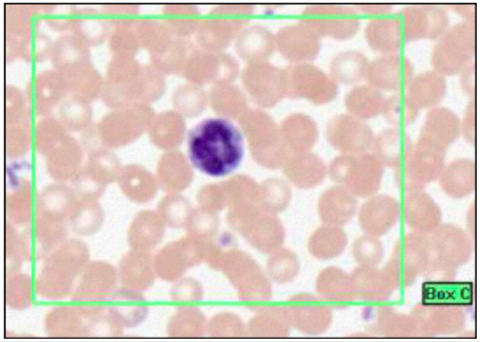
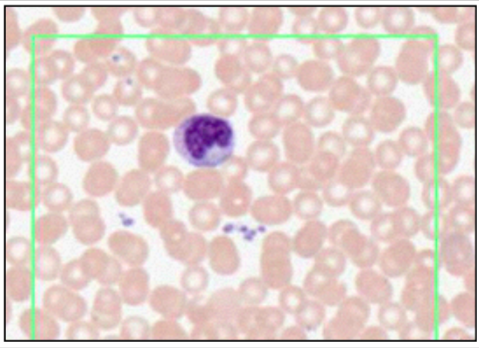
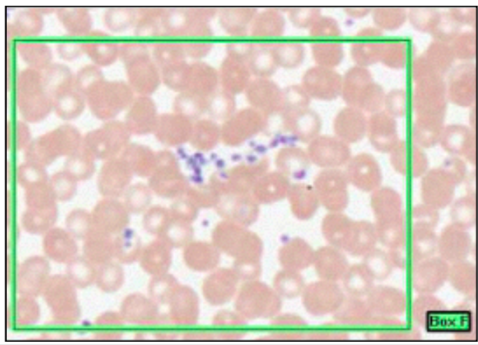

CARDIAC MUSCLE (MYOCARDIUM)
differ from skeletal -

INTERCALATED DISC
disc = black
myofibrial = blue/black
function:
desmosome - anchor one cardiac muscle to next by immediate cytoskeleton filaments
gap junctions - allow ion transfer between cardiac smooth muscle
electrochemical coupling - not cardiac conduction

PURKINJE FIBRES (WITH PAS PROCEDURE - MAGENTA)
CARDIAC CONDUCTION

ARTERY - LEFT, VEIN - RIGHT

MUSCULAR ARTERY

ARTERY WITH PLAQUE AND THROMBUS (WITH IRON HAEMATOXYLIN)

ELASTIC ARTERY (WITH MALLORY’S STAIN)
at top = intima then internal elastic lamina, then vascular endothelial cells on BM

ARTERIOLES
function: highly responsive to vasoactive stimuli - regulation of TPR

CAPILLARIES
this slide - mature adipose

ENDOTHELIAL CELLS (EM)
function:

VENULES

VEINS (TOP LEFT x2)

LARGE VEINS

LYMPH VESSELS
RBC (LEISHMAN’S STAIN - TYPE OF ROMANOVSKY SMEARS)
RETICULOCYTES

EOSINOPHILS (ROMANOVSKY/LEISHMAN’S)
GRANULOCYTES
NEUTROPHILS - POLYMORPHONUCLEAR LEUKOCYTES (LEISHMAN’S STAIN)
fine granules = GRANULOCYTES
lobes = 2-4, number increases with age
BASOPHILS - BASOPHILIC LEUKOCYTES

LYMPHOCYTES
MONOCYTES
in blood and alveolar air spaces
macrophage phagocytotic, actute inflammation, arrive after neutrophils
PLATELETS

MUSCULAR ARTERY 2

ELASTIC TISSUE (ELASTIC VAN GIESON’S WITH IRON HAEMATOXYLIN COUNTER STAIN